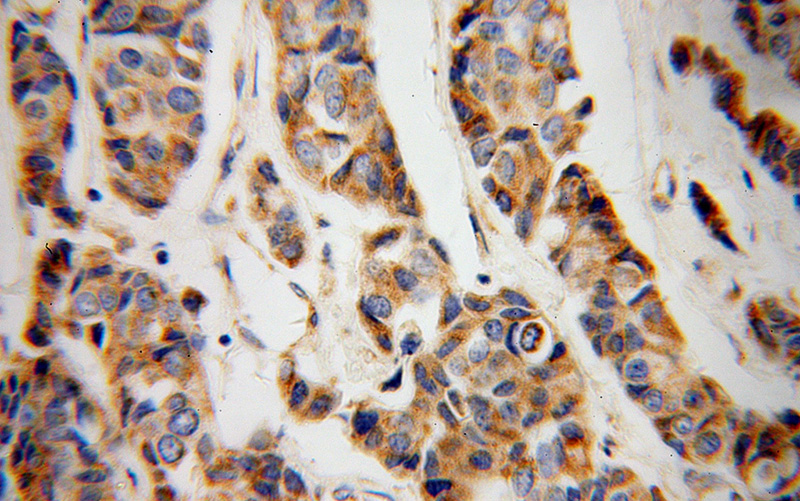
Immunohistochemical of paraffin-embedded human breast cancer using Catalog No:109659(CYC1 antibody) at dilution of 1:100 (under 40x lens)

-
Product Name
CYC1 antibody
- Documents
-
Description
CYC1 Rabbit Polyclonal antibody. Positive WB detected in human brain tissue. Positive IHC detected in human breast cancer tissue. Observed molecular weight by Western-blot: 35 kDa
-
Tested applications
ELISA, WB, IHC
-
Species reactivity
Human; other species not tested.
-
Alternative names
Complex III subunit 4 antibody; Complex III subunit IV antibody; CYC1 antibody; cytOChrome c 1 antibody; UQCR4 antibody
-
Isotype
Rabbit IgG
-
Preparation
This antibody was obtained by immunization of CYC1 recombinant protein (Accession Number: NM_001916). Purification method: Antigen affinity purified.
-
Clonality
Polyclonal
-
Formulation
PBS with 0.1% sodium azide and 50% glycerol pH 7.3.
-
Storage instructions
Store at -20℃. DO NOT ALIQUOT
-
Applications
Recommended Dilution:
WB: 1:500-1:5000
IHC: 1:20-1:200
-
Validations

human brain tissue were subjected to SDS PAGE followed by western blot with Catalog No:109659(CYC1 antibody) at dilution of 1:300

Immunohistochemical of paraffin-embedded human breast cancer using Catalog No:109659(CYC1 antibody) at dilution of 1:100 (under 10x lens)
Immunohistochemical of paraffin-embedded human breast cancer using Catalog No:109659(CYC1 antibody) at dilution of 1:100 (under 40x lens)
-
Background
CYC1, also named as Cytochrome c-1, belongs to the cytochrome c family. Cytochrome c1 is one respiratory subunit of the 11 subunits of the cytochrome bc1 complex of the mitochondrial electron-transfer chain. It mediates the transfer of an electron from Rieske iron-sulfur protein to cytochrome c(PMID:3036122 ). CYC1 mediates apoptosis. In this pathway, a variety of apoptotic stimuli cause CYC1 release from mitochondria, which in turn induces a series of biochemical reactions that result incaspase activation and subsequent cell death.(PMID:15189137) While CYC1 release and DNA fragmentation are unaffected by the noncleavablep75 mutant, mitochondrial morphology of dying cells is maintained, and loss of plasma membrane integrity is delayed(PMID:15186778). The protein migrated as a 35 kd band in SDS page.
-
References
- Lu B, Poirier C, Gaspar T. A mutation in the inner mitochondrial membrane peptidase 2-like gene (Immp2l) affects mitochondrial function and impairs fertility in mice. Biology of reproduction. 78(4):601-10. 2008.
- Li G, Zhang W, Zeng H. An integrative multi-platform analysis for discovering biomarkers of osteosarcoma. BMC cancer. 9:150. 2009.
- Zhu Y, Li M, Wang X. Caspase cleavage of cytochrome c1 disrupts mitochondrial function and enhances cytochrome c release. Cell research. 22(1):127-41. 2012.
- Xiang R, Liu Y, Zhu L, Dong W, Qi Y. Adaptor FADD is recruited by RTN3/HAP in ER-bound signaling complexes. Apoptosis : an international journal on programmed cell death. 11(11):1923-32. 2006.
- Tu JB, Dong Q, Hu XY. Proteomic analysis of mitochondria from infantile hemangioma endothelial cells treated with sodium morrhuate and its liposomal formulation. Journal of biochemical and molecular toxicology. 26(9):374-80. 2012.
- Chen H, Xu L, Yin L. iTRAQ-based proteomic analysis of dioscin on human HCT-116 colon cancer cells. Proteomics. 14(1):51-73. 2014.
- Sun S, Han Y, Liu J. Trichostatin A targets the mitochondrial respiratory chain, increasing mitochondrial reactive oxygen species production to trigger apoptosis in human breast cancer cells. PloS one. 9(3):e91610. 2014.
- Song B, Liu Y, Parman T. Quantitative proteomics for cardiac biomarker discovery using isoproterenol-treated nonhuman primates. Journal of proteome research. 13(12):5909-17. 2014.
Related Products / Services
Please note: All products are "FOR RESEARCH USE ONLY AND ARE NOT INTENDED FOR DIAGNOSTIC OR THERAPEUTIC USE"
